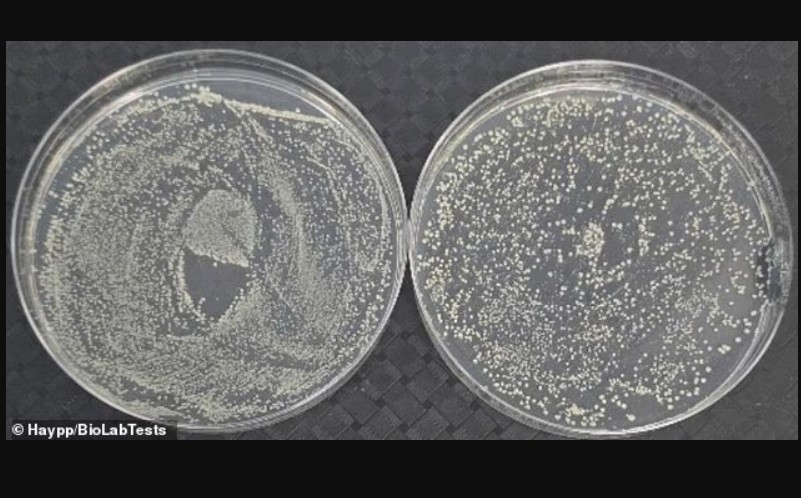
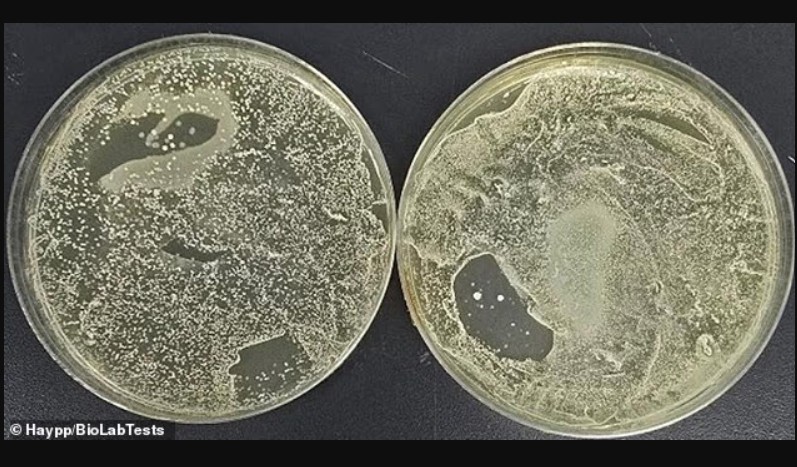
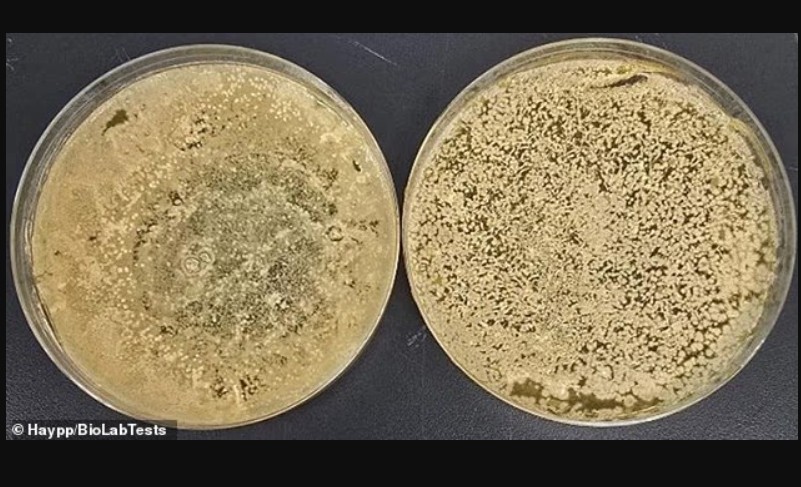

- LajmeShqipëri Maqedoni Shkurt e Shqip Foleja.com Impresum
- Op/Ed
- Sport
Futboll Basketboll Sporte tjera- Roze
Arte Muzike Yjet TV/Film AutoTech Fun Shneta- Te tjera
Lajme
Shqipëri Maqedoni Shkurt e Shqip Foleja.com ImpresumOp/Ed
Sport
Lajme
string(91) "studim-trondites-tymi-e-cigareve-elektronike-eshte-3000-here-me-ndotur-se-nje-kapak-tualeti"Keshilla Mjekësore

Gazeta Express
20/11/2025 19:14Studim tronditës: Tymi e cigareve elektronike është 3,000 herë më ndotur se një kapak tualeti

Keshilla Mjekësore

Gazeta Express
20/11/2025 19:14Një studim i ri laboratorik duhet t’i bëjë përdoruesit e cigareve elektronike të mendojnë dy herë para se ta vendosin “vapen” në gojë.
Sipas shkencëtarëve, avujt e cigareve elektronike janë 3,000 herë më të infektuar me baktere dhe kërpudha sesa një kapak tualeti. Mjedisi i ngrohtë dhe i lagësht i pjesës së gojës së vapës rezulton të jetë terren ideal për shumimin e mikroorganizmave, sidomos kur pajisja nuk pastrohet rregullisht.
“Çdo prekje dhe çdo thithje shton ndotjen,” tha mikrobiologu Reynold Mpofu nga BioLabTests në Coventry. “Ky studim tregon qartë sa i rëndësishëm është pastrimi i rregullt dhe higjiena e lartë për pajisjet e avullimit.”
Vapimi është shndërruar në alternativën më popullore ndaj duhanpirjes tradicionale, me rreth 5.4 milionë përdorues vetëm në Mbretërinë e Bashkuar. Edhe pse konsiderohet më pak i dëmshëm se duhani, një numër në rritje studimesh paralajmërojnë se rreziqet e vërteta të vapimit ende nuk kuptohen plotësisht, duke e lidhur atë me insuficiencë kardiake, sëmundje të mushkërive dhe probleme të rënda të mishrave të dhëmbëve.
Çfarë zbuloi studimi?
BioLabTests, në bashkëpunim me shitësin online të nikotinës Haypp, testuan një vapë Lost Mary me aromë “strawberry ice”. Pajisja u tamponua menjëherë pas hapjes dhe më pas pas 24, 48 dhe 72 orësh, si dhe pas një dhe dy javësh përdorimi.
Rezultatet ishin alarmante:
Brenda 2–3 ditëve, mikrobet u shumuan me mijëra herë.
Ditën e tretë, në grykën e vapës u gjetën rreth 150,000 njësi formuese kolonish (CFU) – kufiri maksimal i matjes së laboratorit.

Për krahasim, një kapak tualeti publik ka rreth 50 CFU për inç katror.
“Pjesa e gojës ishte zona më e ndotur e pajisjes,” tha Mpofu. “Kjo është e pritshme, duke pasur parasysh se goja e njeriut është një nga pjesët më të ndotura të trupit, me rreth 700 lloje bakteresh.”
Edhe trupi i pajisjes rezultoi i kontaminuar rëndë, duke treguar se mikrobet transferohen nga duart e palara, nga xhepat, tryezat, dyshemetë apo sipërfaqe të tjera.
Studiuesit identifikuan:
Bacillus – bakter i zakonshëm në tokë, pluhur e ajër
Staphylococcus – i pranishëm në lëkurën e njeriut
E. coli – bakter fekal i zakonshëm në tualete publike që mund të shkaktojë infeksione
Enterococcus – i lidhur me mjedise të ndotura si banjot publike
Ekspertët dyshojnë se në vapa formohen edhe biofilme, shtresa të ngurta mikrobesh që ngjiten fort dhe pastrohen me vështirësi.
“Ashtu si telefonat, vapat preken vazhdimisht dhe vendosen në sipërfaqe të ndryshme,” tha Mpofu. “Kjo i lejon mikrobeve nga duart, zakonet higjienike të dobëta apo mjedise të pista të kalojnë direkt në pajisje.”
Sa shpesh duhet pastruar vape?
Ekspertët rekomandojnë:
Pastrimin çdo tre ditë, jo një herë në javë siç këshillohet zakonisht online.
Fshirjen me peshqir antibakterial ose me alkool izopropilik.
Për pajisjet me pjesë të ndërrueshme: të çmontohen dhe pastrohen një nga një.
“Pasi e vendosim në gojë, higjiena e vapës duhet të jetë edhe më e rreptë se ajo e telefonit,” tha Markus Lindblad nga Haypp.
Rreziqet e tjera të cigareve elektronike
Megjithëse vapat nuk prodhojnë katran apo monoksid karboni si cigaret tradicionale, ato përmbajnë nikotinë — një substancë tepër varësuese që ngushton enët e gjakut dhe rrit rrezikun e sëmundjeve të zemrës.
Organizata Botërore e Shëndetësisë paralajmëron se vapat janë veçanërisht të rrezikshme për:
Trurin në zhvillim të adoleshentëve
Fetuset gjatë shtatzënisë

Çfarë është një cigare elektronike?
Një cigare elektronike është pajisje që nxehet për të krijuar avull nga një lëng me nikotinë, propilen glikol dhe aromatizues. Nuk ka djegie, prandaj nuk prodhon tym si cigarja tradicionale. Përdorimi masiv dhe dizajnet e reja (si Juul dhe IQOS) i kanë bërë jashtëzakonisht popullore. /GazetaExpress/
Të tjera nga rubrika

Studim tronditës: Tymi e cigareve elektronike është 3,000 herë më ndotur se një kapak tualeti

Mjeku britanik shpjegon pse injeksionet për dobësim nuk janë të përshtatshme për të gjithë: “Mund të rrezikojnë seriozisht shëndetin”

Shkencëtarët ridizenjojnë një ilaç të zakonshëm kundër parazitëve për të vrarë qelizat e kancerit

Trendi i çuditshëm i kujdesit për lëkurën: “Maska menstruale” – gratë vendosin gjakun e menstruacioneve në fytyrë… por a është i shëndetshëm?

Pilula e re kundër obezitetit nga prodhuesi i Mounjaro ul ndjeshëm peshën dhe nivelin e sheqerit në gjak

Sa i “vjetër” është zemra juaj? Kalkulatori online tregon rrezikun e sëmundjeve të zemrës për 30 vitet e ardhshme
Te fundit

Arian Tahiri dedikim votuesve të tij: Faleminderit që më keni dhënë mbështetje, besim dhe forcë në çdo hap

Gjashtë nga dhjetë gazetarë zviceranë janë sulmuar

Gjetën portofolin me para dhe e dorëzuan në polici, Osmani ndan mirënjohje për tre fëmijët nga Ferizaj

Vazhdojnë luftimet mes Rusisë dhe Ukrainës në qytetin e Pokrovskut

Dua Lipa mahniti tifozët në Maracanã gjatë derbit Fluminense-Flamengo

Abdixhiku thirrje qytetarëve në Kosovë dhe mërgatë pas shpalljes së zgjedhjeve: Ndryshimi është në dorën tuaj
✕
 Edicioni
Edicioni
 t7 live
t7 live







